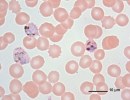

RDTs and ACTs: Diagnostics and Drug Resistance
A recent study (PLoS Medicine) returned some encouraging results regarding Rapid Diagnostic Tests (RDTs) and management of pneumonia and malaria in children in Zambia. We here at CDDEP have written about RDTs in the past, both on their potential to …